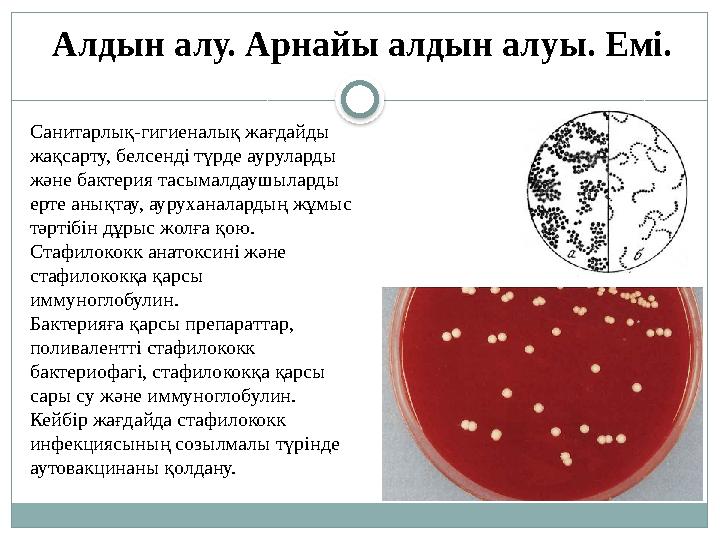
Санитарлық-гигиеналық жағдайды жақсарту, белсенді түрде ауруларды және бактерия тасымалдаушыларды ерте анықтау, ауруханалар

Іріңді қабыну ауруларының қоздырғыштары


#1 слайд
Сабақтың тақырыбы: Іріңді қабыну
ауруларының қоздырғыштары
Жаңаөзен 2025-2026ж
Мамандығы:09130100 – «Мейіргер ісі»
Біліктілігі:4S09130103 – «Жалпы тәжірибедегі мейіргер»
Курс: 2
Оқытушы: Сарыбаева Әсел Дәрібайқызы
Маңғыстау облыстық жоғары медицина колледжі
1 слайд
Сабақтың тақырыбы: Іріңді қабыну ауруларының қоздырғыштары Жаңаөзен 2025-2026ж Мамандығы:09130100 – «Мейіргер ісі» Біліктілігі:4S09130103 – «Жалпы тәжірибедегі мейіргер» Курс: 2 Оқытушы: Сарыбаева Әсел Дәрібайқызы Маңғыстау облыстық жоғары медицина колледжі

#2 слайд
Сабақтың мақсаты:
Іріңді қабыну ауруларының
қоздырғыштарының (стафилакокк,
стрептококк, пневмококк) дакылдық және
морфологиялық қасиеттерін анықтау.
Микробиологиялық әдістерін анықтау,
зерттеу материалдарын жинау.
2 слайд
Сабақтың мақсаты: Іріңді қабыну ауруларының қоздырғыштарының (стафилакокк, стрептококк, пневмококк) дакылдық және морфологиялық қасиеттерін анықтау. Микробиологиялық әдістерін анықтау, зерттеу материалдарын жинау.

#3 слайд
Сабақтың міндеттері
- Іріңді қабыну ауруланын тудыратын грамм оң
және грамм теріс кокктар туралы түсінік беру
- Кокктардың жіктелуін анықтау
- Кокктардың морфологиялық және дақылдық
қасиеттері бойынша түсінік беру.
3 слайд
Сабақтың міндеттері - Іріңді қабыну ауруланын тудыратын грамм оң және грамм теріс кокктар туралы түсінік беру - Кокктардың жіктелуін анықтау - Кокктардың морфологиялық және дақылдық қасиеттері бойынша түсінік беру.

#4 слайд
1.ЖАЛПЫ КОККТАРДЫҢ ЖІКТЕЛУІ
2.СТАФИЛАКОКК ҚОЗДЫРҒЫШЫНЫҢ
ДАҚЫЛДЫҚ,МОРФОЛГИЯЛЫҚ,ҚОРШАҒАН
ОРТА ФАКТОРЛАРЫНА ТӨЗІМДІЛІГІ
3.СТРЕПТОКОКК ҚОЗДЫРҒЫШЫНЫҢ
АДАМДА ТУҒЫЗАТЫН АУРУЛАРЫ
4.ПНЕВМОКОКК ҚОЗДЫРҒЫШЫНЫҢ ТАРАЛУ
ЖОЛДАРЫ, АЛДЫН АЛУЫ ЖӘНЕ ЕМІ
Сабақтың жоспары
4 слайд
1.ЖАЛПЫ КОККТАРДЫҢ ЖІКТЕЛУІ 2.СТАФИЛАКОКК ҚОЗДЫРҒЫШЫНЫҢ ДАҚЫЛДЫҚ,МОРФОЛГИЯЛЫҚ,ҚОРШАҒАН ОРТА ФАКТОРЛАРЫНА ТӨЗІМДІЛІГІ 3.СТРЕПТОКОКК ҚОЗДЫРҒЫШЫНЫҢ АДАМДА ТУҒЫЗАТЫН АУРУЛАРЫ 4.ПНЕВМОКОКК ҚОЗДЫРҒЫШЫНЫҢ ТАРАЛУ ЖОЛДАРЫ, АЛДЫН АЛУЫ ЖӘНЕ ЕМІ Сабақтың жоспары

#5 слайд
- Іріңді қабыну ауруларының қоздырғыштарының
түрлерін ажырата біледі;
- Грамм оң және грамм теріс кокктарды ажырата
біледі;
- Кокктардың дақылдық және морфологиялық
қасиеттерін салыстыра отыра анықтай алады;
- Кокктардың адамда туғызатын ауруларын анықтай
алады;
Бүгінгі сабақтың бағалау
критерийлері:
5 слайд
- Іріңді қабыну ауруларының қоздырғыштарының түрлерін ажырата біледі; - Грамм оң және грамм теріс кокктарды ажырата біледі; - Кокктардың дақылдық және морфологиялық қасиеттерін салыстыра отыра анықтай алады; - Кокктардың адамда туғызатын ауруларын анықтай алады; Бүгінгі сабақтың бағалау критерийлері:

#6 слайд
Іріңді қабыну ауруларын кокктар туғызады. Кокктар-бұл
микроағзалардың үлкен тобы. Бұл топтың патогенді, щартты патогенді
және патогенді емес өкілдері болады.
Берги жіктелуі бойынша кокктар үш тұқымдастыққа жатады.
Стафилококктар
Стрептококктар мен пневмококктар
Менингококктар мен гонококктар
Барлық патогенді кокктарға жалпы ортақ қасиет – ол іріңді процесті
туындату қабілеті, сондықтан оларды іріңді кокктар деп атайды.
Патогенді кокктардың барлығы қозғалмайды,спора түзбейді, тек
пневмококктар ғана капсула түзеді.
Тикториалдық қасиетіне байланысты грамм оң және грамм теріс болып
бөлінеді.
Кокктар туралы жалпы түсінік
6 слайд
Іріңді қабыну ауруларын кокктар туғызады. Кокктар-бұл микроағзалардың үлкен тобы. Бұл топтың патогенді, щартты патогенді және патогенді емес өкілдері болады. Берги жіктелуі бойынша кокктар үш тұқымдастыққа жатады. Стафилококктар Стрептококктар мен пневмококктар Менингококктар мен гонококктар Барлық патогенді кокктарға жалпы ортақ қасиет – ол іріңді процесті туындату қабілеті, сондықтан оларды іріңді кокктар деп атайды. Патогенді кокктардың барлығы қозғалмайды,спора түзбейді, тек пневмококктар ғана капсула түзеді. Тикториалдық қасиетіне байланысты грамм оң және грамм теріс болып бөлінеді. Кокктар туралы жалпы түсінік

#7 слайд
Дақылдануы. Стафилакокктар факультативті анаэробтар, дегенмен оттегі
бар жерде жақсы өседі. Қарапайым қоретік ортада өседі және өнеді, қан
қосылған қоректік ортада жақсы өседі, қолайлы температурасы 37°С және
рН 7,2-7,4.
Элективті қоректік орталарға сары уызды тұздар агар мен тұзды агар жатады.
Ет пептонды агарда (ЕПА) стафилакокктар дөңестелген, домалақ, мөлдір
емес, жалтыраған, көлемі 2-4мм, шеттері тегіс колония түзеді.
Стафилакокктар
Морфологиясы. Стафилакокктар (грек сөзі
Staphyle – жүзім шоғыры) домалақ шар
тәрізді, диаметрі 0,5-1,5мкм. Көбейгенде
жүзімнің шоғыры секілді топталады және
қозғалмайды, спорасы жоқ, грамм оң
боялады.
7 слайд
Дақылдануы. Стафилакокктар факультативті анаэробтар, дегенмен оттегі бар жерде жақсы өседі. Қарапайым қоретік ортада өседі және өнеді, қан қосылған қоректік ортада жақсы өседі, қолайлы температурасы 37°С және рН 7,2-7,4. Элективті қоректік орталарға сары уызды тұздар агар мен тұзды агар жатады. Ет пептонды агарда (ЕПА) стафилакокктар дөңестелген, домалақ, мөлдір емес, жалтыраған, көлемі 2-4мм, шеттері тегіс колония түзеді. Стафилакокктар Морфологиясы. Стафилакокктар (грек сөзі Staphyle – жүзім шоғыры) домалақ шар тәрізді, диаметрі 0,5-1,5мкм. Көбейгенде жүзімнің шоғыры секілді топталады және қозғалмайды, спорасы жоқ, грамм оң боялады.

#8 слайд
Қоршаған орта факторларына төзімділігі.
Стафилококктар едәуір төзімді, сондықтан олар ауадан, топырақтан, судан,
тұрмыстық заттардан табыла береді. 100*С температурада олар бірден, ал
70*С температурада 10-15 минутта өледі. Олар төменгі температурада
жақсы сақталады. Қатырғанда тіршілігін бірнеше жылдар бойы сақталады.
Кептіргенге төзімді. Тікелей түскен күн сәулесі оларды тек бірнеше
сағаттан кейін өлтіреді. Зарарсыздандыру ерітінділері 15-20 минуттан кейін
өлтіреді.
Инфекция көзі. Ауру адам және бактерия тасымалдаушы.
Жұғу жолдары. Тұрмыстық қатынас, ауа-тамшы, ауа-шаң, тағам арқылы.
Бөртпелер, жаралар, сыздауықтар, күбірткелер, абцесстер,әртүрлі мүшелер
мен ұлпалардың қабыну процестері, баспа, цистит, остеомиелит,
холецистит, мастит, сепсис және септикопиемия, тағамдық
токсикоинфекция және т.б.
8 слайд
Қоршаған орта факторларына төзімділігі. Стафилококктар едәуір төзімді, сондықтан олар ауадан, топырақтан, судан, тұрмыстық заттардан табыла береді. 100*С температурада олар бірден, ал 70*С температурада 10-15 минутта өледі. Олар төменгі температурада жақсы сақталады. Қатырғанда тіршілігін бірнеше жылдар бойы сақталады. Кептіргенге төзімді. Тікелей түскен күн сәулесі оларды тек бірнеше сағаттан кейін өлтіреді. Зарарсыздандыру ерітінділері 15-20 минуттан кейін өлтіреді. Инфекция көзі. Ауру адам және бактерия тасымалдаушы. Жұғу жолдары. Тұрмыстық қатынас, ауа-тамшы, ауа-шаң, тағам арқылы. Бөртпелер, жаралар, сыздауықтар, күбірткелер, абцесстер,әртүрлі мүшелер мен ұлпалардың қабыну процестері, баспа, цистит, остеомиелит, холецистит, мастит, сепсис және септикопиемия, тағамдық токсикоинфекция және т.б.

#9 слайд
Адамдағы аурулары
*Бөртпелер
*жаралар
*сыздауықтар
*күбірткелер
*абцесстер
*әртүрлі мүшелер мен
ұлпалардың қабыну
процестері
*баспа
*цистит
*остеомиелит
*холецистит
*мастит
*сепсис және
септикопиемия, тағамдық
токсикоинфекция және т.б.
9 слайд
Адамдағы аурулары *Бөртпелер *жаралар *сыздауықтар *күбірткелер *абцесстер *әртүрлі мүшелер мен ұлпалардың қабыну процестері *баспа *цистит *остеомиелит *холецистит *мастит *сепсис және септикопиемия, тағамдық токсикоинфекция және т.б.
#10 слайд
Санитарлық-гигиеналық жағдайды
жақсарту, белсенді түрде ауруларды
және бактерия тасымалдаушыларды
ерте анықтау, ауруханалардың жұмыс
тәртібін дұрыс жолға қою.
Стафилококк анатоксині және
стафилококқа қарсы
иммуноглобулин.
Бактерияға қарсы препараттар,
поливалентті стафилококк
бактериофагі, стафилококқа қарсы
сары су және иммуноглобулин.
Кейбір жағдайда стафилококк
инфекциясының созылмалы түрінде
аутовакцинаны қолдану.
Алдын алу. Арнайы алдын алуы. Емі.
10 слайд
Санитарлық-гигиеналық жағдайды жақсарту, белсенді түрде ауруларды және бактерия тасымалдаушыларды ерте анықтау, ауруханалардың жұмыс тәртібін дұрыс жолға қою. Стафилококк анатоксині және стафилококқа қарсы иммуноглобулин. Бактерияға қарсы препараттар, поливалентті стафилококк бактериофагі, стафилококқа қарсы сары су және иммуноглобулин. Кейбір жағдайда стафилококк инфекциясының созылмалы түрінде аутовакцинаны қолдану. Алдын алу. Арнайы алдын алуы. Емі.

#11 слайд
Стрептококктар
Морфологиясы. Стрептококктар
шар тәрізді кокктар. Диаметрі 0,6-1
мкм, шар тәрізді болып келеді. Бір
жазықтықта бөлінудің нәтижесінде
стрептококктар тізбектеліп
орналасады. Қозғалмайды, спора
түзбейді, грамм оң. Дақылдануы.
Стрептококктар факультативті
анаэробтар. 37*С температурада
өседі және рН 7,6-7,8. Құрамында
қан немесе қанның сарысуы бар
қоректік орталар олардың өсіп
өнуіне қолайлы. Тығыз қоректік
ортада стрептококктардың
колониясы майда, жалпақ, мөлдір
емес, сұр түсті.
11 слайд
Стрептококктар Морфологиясы. Стрептококктар шар тәрізді кокктар. Диаметрі 0,6-1 мкм, шар тәрізді болып келеді. Бір жазықтықта бөлінудің нәтижесінде стрептококктар тізбектеліп орналасады. Қозғалмайды, спора түзбейді, грамм оң. Дақылдануы. Стрептококктар факультативті анаэробтар. 37*С температурада өседі және рН 7,6-7,8. Құрамында қан немесе қанның сарысуы бар қоректік орталар олардың өсіп өнуіне қолайлы. Тығыз қоректік ортада стрептококктардың колониясы майда, жалпақ, мөлдір емес, сұр түсті.

#12 слайд
Стрептококктар қоршаған ортада төзімді.
60°С температурада 30 минуттан кейін
өледі. Кепкен іріңмен қақырықта айлар
бойы сақталады. Қолданыстағы
залалсызландыру ертінділері 15-20
минуттан кейін өлтіреді.
Инфекция көзі. Ауру адам және
бактериятасымалдаушы. Қоздырғышпен
ластанған тағамдар мен жануарлар сирек
инфекция көзі болады.
Таралу жолы. Ауа-тамшы және ауа-шаң,
кейбір жағдайларда тағам арқылы және
тұрмыстық қатынастар арқылы да
берілуде мүмкін.
Емі. Антибиотиктер қолданылады,
әсіресе эритромицин, тетрациклин,
пенициллин.
Қоршаған ортаның факторларына төзімділігі.
12 слайд
Стрептококктар қоршаған ортада төзімді. 60°С температурада 30 минуттан кейін өледі. Кепкен іріңмен қақырықта айлар бойы сақталады. Қолданыстағы залалсызландыру ертінділері 15-20 минуттан кейін өлтіреді. Инфекция көзі. Ауру адам және бактериятасымалдаушы. Қоздырғышпен ластанған тағамдар мен жануарлар сирек инфекция көзі болады. Таралу жолы. Ауа-тамшы және ауа-шаң, кейбір жағдайларда тағам арқылы және тұрмыстық қатынастар арқылы да берілуде мүмкін. Емі. Антибиотиктер қолданылады, әсіресе эритромицин, тетрациклин, пенициллин. Қоршаған ортаның факторларына төзімділігі.

#13 слайд
Стрептококктар адамда жұқпаның
жедел және созылмалы түрлерін
туындатыды.олар іріңді және іріңді
емес болады.
Іріңділері – флегмоналар, абцестер,
жаралар.
Іріңді емес – тыныс алу жолдарының
жедел инфекциясы, скарлатина,
ревматизм, тері қабынуы. Тұмау,
қызылша, көкжөтел кезінде
стрептококктарекіншілік инфекцияны
жиі туындатады және жара
инфекцияларның асқындыру.
Стрептококктардың адамда
туғызатын аурлары
13 слайд
Стрептококктар адамда жұқпаның жедел және созылмалы түрлерін туындатыды.олар іріңді және іріңді емес болады. Іріңділері – флегмоналар, абцестер, жаралар. Іріңді емес – тыныс алу жолдарының жедел инфекциясы, скарлатина, ревматизм, тері қабынуы. Тұмау, қызылша, көкжөтел кезінде стрептококктарекіншілік инфекцияны жиі туындатады және жара инфекцияларның асқындыру. Стрептококктардың адамда туғызатын аурлары

#14 слайд
Пневмококктар
1871 жылы бірінші рет Р.Кох пневмококктарды сипаттаған.
Морфологиясы. Пневмококктар – диплококктар, екі-екуден орналасұқан, жалпақ
жағы бір-біріне қараған, екінші жағы созылыңқы, жанып тұрған шыраққа ұқсайды.
Пневмококктардың өлшемі 0,75-0,5х 0,5-1мкм, жұптармен орналасқан. Сұйық
қоректік ортада тізбектеліп орналасады. Пневмококктар қозғалмайды, спорасы жоқ,
ағзада екі кокктыда қоршайтын капсула түзеді. пневмококктар грамм оң, ескі
дакылдарында грамм теріс бактериялар кездеседі.
14 слайд
Пневмококктар 1871 жылы бірінші рет Р.Кох пневмококктарды сипаттаған. Морфологиясы. Пневмококктар – диплококктар, екі-екуден орналасұқан, жалпақ жағы бір-біріне қараған, екінші жағы созылыңқы, жанып тұрған шыраққа ұқсайды. Пневмококктардың өлшемі 0,75-0,5х 0,5-1мкм, жұптармен орналасқан. Сұйық қоректік ортада тізбектеліп орналасады. Пневмококктар қозғалмайды, спорасы жоқ, ағзада екі кокктыда қоршайтын капсула түзеді. пневмококктар грамм оң, ескі дакылдарында грамм теріс бактериялар кездеседі.

#15 слайд
Пневмококктар – факультативті
анаэробтар. 36°-37°С температурада
рН 7,2-7,4 ортада өседі. Қоректік орта
құрамында ақуыздар, қан мен
сарысуды қосылғанын талап етеді.
Қоршаған орта факторларына
төзімділігі. Пневмококктардың
төзімділігі нашар. 60°С температурада
2-3минуттан кейін өледі. Төменгі
температураға және кептіргенге
төзімді. Құрғақ қақырықта тіршілікке
қабілеттілігі 2 айға дейін сақталады.
Қоректік ортада сақталуы 5-6 күннен
аспайды, сондықтан әр 2-3 күн сайын
егуді қайталау керек.
Жануарлардың
қабылдағыштығы .
Пневмококктардың табиғаттағы
қожайыны адам. Дегенменде
пневмококктар бұзауда, қозыда, итте,
маймылда ауры туындатады.
Дақылдануы.
15 слайд
Пневмококктар – факультативті анаэробтар. 36°-37°С температурада рН 7,2-7,4 ортада өседі. Қоректік орта құрамында ақуыздар, қан мен сарысуды қосылғанын талап етеді. Қоршаған орта факторларына төзімділігі. Пневмококктардың төзімділігі нашар. 60°С температурада 2-3минуттан кейін өледі. Төменгі температураға және кептіргенге төзімді. Құрғақ қақырықта тіршілікке қабілеттілігі 2 айға дейін сақталады. Қоректік ортада сақталуы 5-6 күннен аспайды, сондықтан әр 2-3 күн сайын егуді қайталау керек. Жануарлардың қабылдағыштығы . Пневмококктардың табиғаттағы қожайыны адам. Дегенменде пневмококктар бұзауда, қозыда, итте, маймылда ауры туындатады. Дақылдануы.

#16 слайд
•Өкпе қабынуы-
крупозды пневмония
•Көздің жылжымалы
жарасы.
•Құлақтың қабынуы.
Адамдағы аурулары.
16 слайд
•Өкпе қабынуы- крупозды пневмония •Көздің жылжымалы жарасы. •Құлақтың қабынуы. Адамдағы аурулары.

#17 слайд
Ауру адам және бактериятасымалдаушы.
Таралу жолдары. Ауа-тамшы, ауа-шаң арқылы таралады.
Ағзаға ену жолдары. Тыныс жолдарының, көздің, құлақтың шырышты
қабаты.
Иммунитеті. Аурудан айыққаннан кейін иммунитет сақталмайды,
өйткені ауру қайталана береді.
Алдын алу. Санитарлық –гигеналық шараларды жүзеге асыру.
Емі. Антибиотиктер қолданылады-тетрациклин, пенициллин.
Инфекция көзі.
17 слайд
Ауру адам және бактериятасымалдаушы. Таралу жолдары. Ауа-тамшы, ауа-шаң арқылы таралады. Ағзаға ену жолдары. Тыныс жолдарының, көздің, құлақтың шырышты қабаты. Иммунитеті. Аурудан айыққаннан кейін иммунитет сақталмайды, өйткені ауру қайталана береді. Алдын алу. Санитарлық –гигеналық шараларды жүзеге асыру. Емі. Антибиотиктер қолданылады-тетрациклин, пенициллин. Инфекция көзі.

#18 слайд
Сабақты бекіту, қортындылау тапсырмалары
Кестені толтыру
Кокктар Дақылдануы
Морфологиясы
Қоршаған орта
факторларына
төзімділігі
Адамдағы
аурулары
Таралу жолдары мен
алдын алуы және емдеуі
1.Стафилакокк
2. Стрептококк
3.Пневмококк
18 слайд
Сабақты бекіту, қортындылау тапсырмалары Кестені толтыру Кокктар Дақылдануы Морфологиясы Қоршаған орта факторларына төзімділігі Адамдағы аурулары Таралу жолдары мен алдын алуы және емдеуі 1.Стафилакокк 2. Стрептококк 3.Пневмококк

#19 слайд
Кестенің жауабы:
Кокктар Дақылдануы
Морфологиясы
Қоршаған орта факторларына
төзімділігі
Адамдағы аурулары Таралу жолдары мен алдын
алуы және емдеуі
1.СтафилакоккКөбейгенде жүзімнің
шоғыры секілді
топталады. Қарапайым
қоретік ортада
өседі,қолайлы
температурасы 37°С және
рН 7,2-7,4.
Ауадан, топырақтан, судан,
тұрмыстық заттардан табыла
береді. 100*С температурада
олар бірден, ал 70*С
температурада 10-15 минутта
өледі
Бөртпелер, жаралар,
сыздауықтар,
күбірткелер,
абцесстер,әртүрлі
мүшелер мен
ұлпалардың қабыну
процестері, баспа,
цистит,
Бактерияға қарсы препараттар.
Ауру адам және бактерия
тасымалдаушы.
Тұрмыстық қатынас, ауа-
тамшы, ауа-шаң, тағам арқылы.
2. СтрептококкФакультативті
анаэробтар. 37*С тем
өседі және рН 7,6-7,8. қан
немесе қанның сарысуы
бар қоректік орталар
олардың өсіп өнуіне
қолайлы. стрептококктар
тізбектеліп орналасады.
Стрептококктар қоршаған
ортада төзімді. 60°С
температурада 30 минуттан
кейін өледі. Кепкен іріңмен
қақырықта айлар бойы
сақталады. Қолданыстағы
залалсызландыру ертінділері
15-20 өлтіреді.
Іріңділері –
флегмоналар, абцестер,
жаралар. Іріңді емес –
тыныс алу жолдарының
жедел инфекциясы,
скарлатина, ревматизм,
тері қабынуы.
Ауа-шаң, кейбір жағдайларда
тағам арқылы және тұрмыстық
қатынастар арқылы. Ағзаның
жалпы төзімдлігін арттыру.
Эритромицин, тетрациклин,
пенициллин.
3.ПневмококкДиплококктар, екі-екуден
орналасқан. грамм оң.
факультативті
анаэробтар. 36°-37°С
темрН 7,2-7,4 ортада
өседі. Қоректік орта
құрамында ақуыздар, қан
қосылғанын талап етеді.
Пневмококктардың
төзімділігі нашар. 60°С
температурада 2-3минуттан
кейін өледі. Төменгі
температураға және
кептіргенге төзімді. Құрғақ
қақырықта тіршілікке
қабілеттілігі 2 айға дейін
сақталады.
Өкпе қабынуы-крупозды
пневмония.Көздің
жылжымалы
жарасы.Құлақтың
қабынуы.
Санитарлық –гигеналық
шараларды жүзеге асыру. Ауа-
тамшы. Тетрациклин,
пенициллин
19 слайд
Кестенің жауабы: Кокктар Дақылдануы Морфологиясы Қоршаған орта факторларына төзімділігі Адамдағы аурулары Таралу жолдары мен алдын алуы және емдеуі 1.СтафилакоккКөбейгенде жүзімнің шоғыры секілді топталады. Қарапайым қоретік ортада өседі,қолайлы температурасы 37°С және рН 7,2-7,4. Ауадан, топырақтан, судан, тұрмыстық заттардан табыла береді. 100*С температурада олар бірден, ал 70*С температурада 10-15 минутта өледі Бөртпелер, жаралар, сыздауықтар, күбірткелер, абцесстер,әртүрлі мүшелер мен ұлпалардың қабыну процестері, баспа, цистит, Бактерияға қарсы препараттар. Ауру адам және бактерия тасымалдаушы. Тұрмыстық қатынас, ауа- тамшы, ауа-шаң, тағам арқылы. 2. СтрептококкФакультативті анаэробтар. 37*С тем өседі және рН 7,6-7,8. қан немесе қанның сарысуы бар қоректік орталар олардың өсіп өнуіне қолайлы. стрептококктар тізбектеліп орналасады. Стрептококктар қоршаған ортада төзімді. 60°С температурада 30 минуттан кейін өледі. Кепкен іріңмен қақырықта айлар бойы сақталады. Қолданыстағы залалсызландыру ертінділері 15-20 өлтіреді. Іріңділері – флегмоналар, абцестер, жаралар. Іріңді емес – тыныс алу жолдарының жедел инфекциясы, скарлатина, ревматизм, тері қабынуы. Ауа-шаң, кейбір жағдайларда тағам арқылы және тұрмыстық қатынастар арқылы. Ағзаның жалпы төзімдлігін арттыру. Эритромицин, тетрациклин, пенициллин. 3.ПневмококкДиплококктар, екі-екуден орналасқан. грамм оң. факультативті анаэробтар. 36°-37°С темрН 7,2-7,4 ортада өседі. Қоректік орта құрамында ақуыздар, қан қосылғанын талап етеді. Пневмококктардың төзімділігі нашар. 60°С температурада 2-3минуттан кейін өледі. Төменгі температураға және кептіргенге төзімді. Құрғақ қақырықта тіршілікке қабілеттілігі 2 айға дейін сақталады. Өкпе қабынуы-крупозды пневмония.Көздің жылжымалы жарасы.Құлақтың қабынуы. Санитарлық –гигеналық шараларды жүзеге асыру. Ауа- тамшы. Тетрациклин, пенициллин

#20 слайд
Жағдаяттық есепті
шешеміз
1 есеп. Пневмониямен ауыратын науқастың қақырығы лаборторияға
әкелінді.Оны ақ тышқандарға жұқтырды. 10 сағаттан кейін ақ тышқандар өлді.
Жарып тексергенде Грамм оң боялатын, капсуласы бар, жұп-жұптан
орналасқан кокктарды ішкі ағзадан жағынды жасағанда тапты. Қандай
қоздырғыш деп ойлайсыз? Капсуланы қандай әдіспен анықтайды?
2 есеп. Грамша боялған жағындыда күлгін көк түсті таяқшалар, орташа
мөлшерлі, екі шеттері домалақтанып біткен және жүзім тәрізді орналасқан
күлгін кокктар табылды. Микробтың түрі анықтаңыз және Грамша боялу
сипаты.
20 слайд
Жағдаяттық есепті шешеміз 1 есеп. Пневмониямен ауыратын науқастың қақырығы лаборторияға әкелінді.Оны ақ тышқандарға жұқтырды. 10 сағаттан кейін ақ тышқандар өлді. Жарып тексергенде Грамм оң боялатын, капсуласы бар, жұп-жұптан орналасқан кокктарды ішкі ағзадан жағынды жасағанда тапты. Қандай қоздырғыш деп ойлайсыз? Капсуланы қандай әдіспен анықтайды? 2 есеп. Грамша боялған жағындыда күлгін көк түсті таяқшалар, орташа мөлшерлі, екі шеттері домалақтанып біткен және жүзім тәрізді орналасқан күлгін кокктар табылды. Микробтың түрі анықтаңыз және Грамша боялу сипаты.

#21 слайд
1 есеп. Бұл қоздырғыш пневмококк. Грамм оң боялған, жұп-жұптан орналасқан,
капсулсы бар. Капсуланы Бурри әдісімен анықтаймыз.
2 есеп. Стафилакокк қоздырғышы, грамм оң боялған. Күлгін көк түсті, жүзім
шоғыры сияқты топталып өмір сүреді.
Жағдаяттық есептін жауабы
21 слайд
1 есеп. Бұл қоздырғыш пневмококк. Грамм оң боялған, жұп-жұптан орналасқан, капсулсы бар. Капсуланы Бурри әдісімен анықтаймыз. 2 есеп. Стафилакокк қоздырғышы, грамм оң боялған. Күлгін көк түсті, жүзім шоғыры сияқты топталып өмір сүреді. Жағдаяттық есептін жауабы

#22 слайд
Тапсырмалардың бағалау критерийлері
Тапсырма түрлері Критерийі Дискриптор балл
Кестені толтыр Қоздырғыштар туралы
толық мәліметті біледі
Нақты және толық
жауап береді
4
Жауап толық емес 2
Қоздырғыштар бойынша
венндиаграмманы
толтыр
Қоздырғыштардың
ұқсастығымен
айырмашылығын
нақты ажырата алады
Нақты ажыратып
толық толтырған
2
Қатемен орындалған 1
Жағдаяттық есепті
шешеу
Жағдаяттық есепті
берілген тапсырма
бойынша шеше біледі
Дәлел келтіре отырып
дұрыс нақты жауап
береді
4
Толық емес жауап 2
Бағалау рейтингі:
•8-10 жауап -90-100%
•5-8 жауап – 75-85%
•2-5 жауап – 50-75%
•0-1 жауап – 0-49%
22 слайд
Тапсырмалардың бағалау критерийлері Тапсырма түрлері Критерийі Дискриптор балл Кестені толтыр Қоздырғыштар туралы толық мәліметті біледі Нақты және толық жауап береді 4 Жауап толық емес 2 Қоздырғыштар бойынша венндиаграмманы толтыр Қоздырғыштардың ұқсастығымен айырмашылығын нақты ажырата алады Нақты ажыратып толық толтырған 2 Қатемен орындалған 1 Жағдаяттық есепті шешеу Жағдаяттық есепті берілген тапсырма бойынша шеше біледі Дәлел келтіре отырып дұрыс нақты жауап береді 4 Толық емес жауап 2 Бағалау рейтингі: •8-10 жауап -90-100% •5-8 жауап – 75-85% •2-5 жауап – 50-75% •0-1 жауап – 0-49%

#23 слайд
Кері байланыс. Рефлекция
Білемін...............
Білгім келеді.................
Сұрағым бар........
23 слайд
Кері байланыс. Рефлекция Білемін............... Білгім келеді................. Сұрағым бар........

#24 слайд
Үйге тапсырмалар
1.Іріңді қабыну ауруларын қандай микроағза
туғызады?
2. Кокктар Берги жіктелуі бойынша қаншаға
бөлінеді?
3. Грамм оң кокктар?
4. Грамм теріс кокктар?
5. Стафилакокктар адамда қандай ауру туғызады?
6. Стрептококктар адамдағы ауруларын атаңыз?
7. Пневмококктардың адамдағы аурулары?
2.Тақрыпқа сәйкес жағдаяттық есеп құрастыру және
кластер жасау.
24 слайд
Үйге тапсырмалар 1.Іріңді қабыну ауруларын қандай микроағза туғызады? 2. Кокктар Берги жіктелуі бойынша қаншаға бөлінеді? 3. Грамм оң кокктар? 4. Грамм теріс кокктар? 5. Стафилакокктар адамда қандай ауру туғызады? 6. Стрептококктар адамдағы ауруларын атаңыз? 7. Пневмококктардың адамдағы аурулары? 2.Тақрыпқа сәйкес жағдаяттық есеп құрастыру және кластер жасау.

шағым қалдыра аласыз






 Бұл курс Қазақстан Республикасы Оқу-ағарту министрлігімен келісілген
Бұл курс Қазақстан Республикасы Оқу-ағарту министрлігімен келісілген
